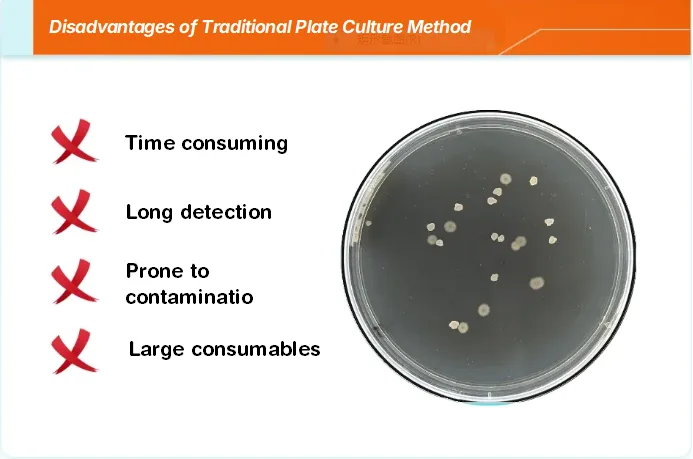

As a popular consumer product, beverage safety and quality standards are highly valued by consumers and regulatory authorities in today’s food industry. Beverages, including and not limited to bottled water, fruit juices, carbonated drinks, dairy products, and functional beverages, are prone to becoming grounds for microorganisms due to their abundant nutritional components and suitable moisture conditions. Therefore, conducting microbiological tests on beverages is crucial to ensure their safety and prolong their shelf life.
The traditional plate culture method is a widely used microbial detection technique, it performs microbial analysis by smearing or dropping the sample onto a culture medium, then observing and counting the grown colonies. However, there are risks such as long detection times, high consumption of materials, and susceptibility to contamination for this method. Additionally, it cannot promptly characterize microbial contamination when addressing such issues.

To cope with this challenge and enhance the quality control of products, Tailin launched the Microbial Detection Analyzer MD500 to detect microbial content in beverages.
Rapid microbial detection is crucial for early warning systems as it can identify potential risks. To this end, Tailin collected several common beverages on the market and used the Microbial Detection Analyzer to conduct microbial tests on them.


Sample 1 Drinking water (distilled water): microbial concentration 6 AFU/10 mL, inert particle concentration 8444 particles/10 mL;
Sample 2 Drinking water (mineral water): microbial concentration 2 AFU/10 mL, inert particle concentration 4423 particles/10 mL;
Sample 3 Tea-based beverage (yellow): microbial concentration 5 AFU/10 mL, inert particle concentration 82988 particles/10 mL;
Sample 4 Vitamin beverage (yellow): microbial concentration 1 AFU/10 mL, inert particle concentration 29226 particles/10 mL.


Tailin carried out rapid microbial detection on four common beverages on the market, which could display the microbial content in the beverages in real time and accurately, providing an efficient and accurate detection method for food safety supervision. Through this technology, microbial contamination can be detected and controlled promptly to protect consumers’ health. Meanwhile, it provides the scientific basis for beverage manufacturers to improve product quality.